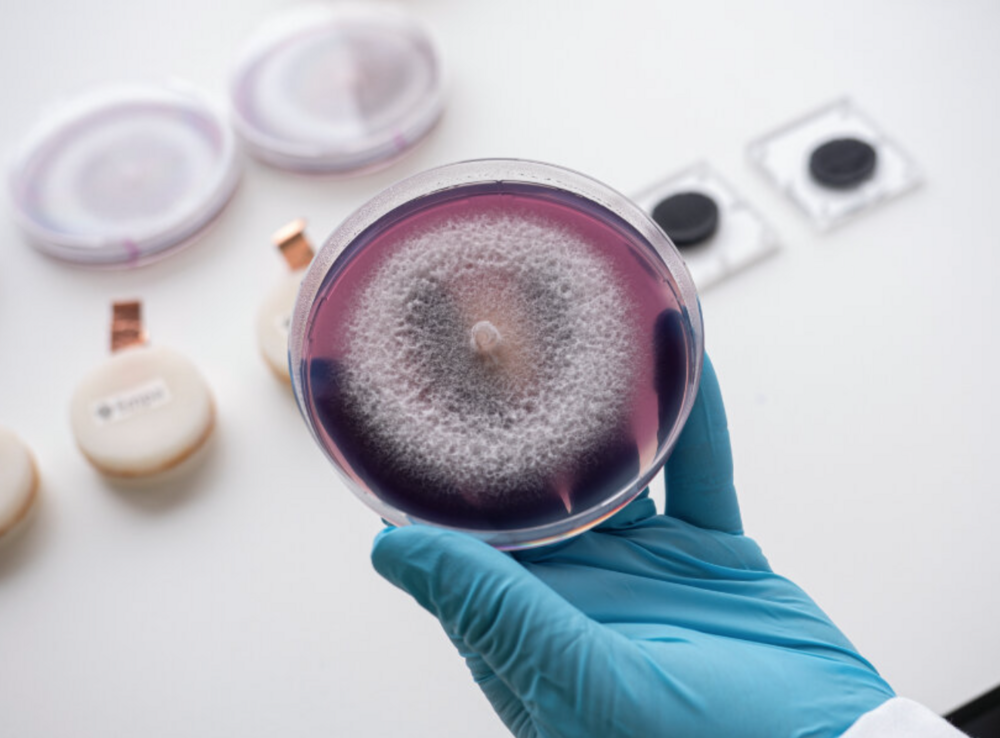
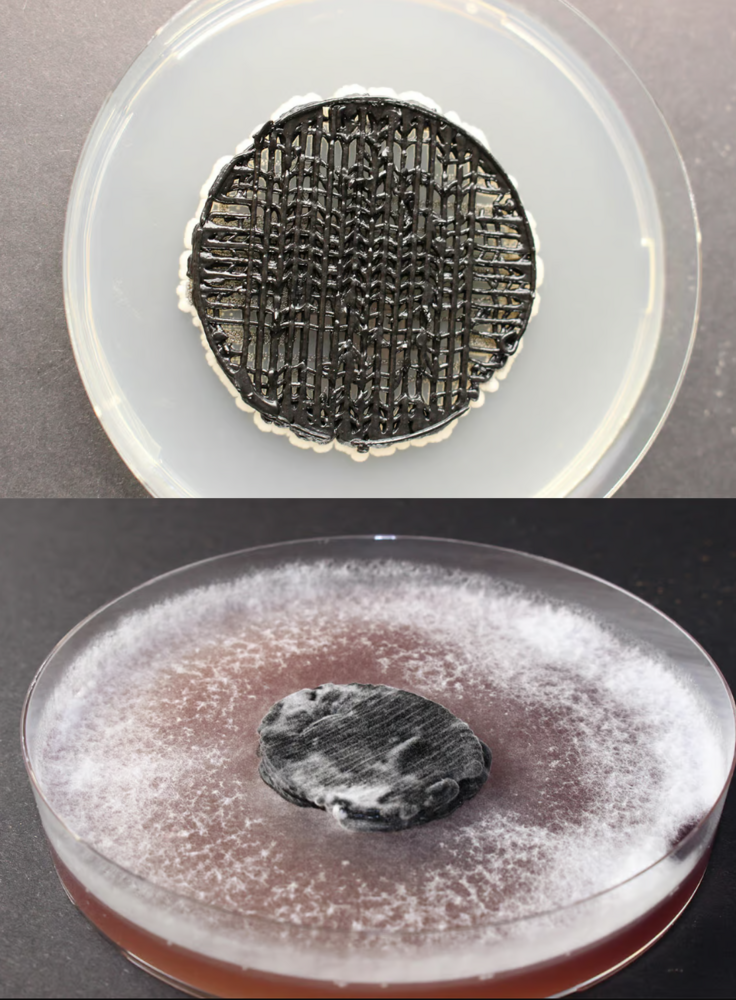

Empa‘nın (İsviçre Federal Malzeme Bilimi ve Teknolojisi Laboratuvarları) Selüloz ve Ahşap Malzemeler bölümündeki araştırmacılar tarafından geliştirilen pil, sensörler gibi küçük cihazlara birkaç gün boyunca güç sağlayabiliyor. Bunu yapabilmek için de şekeri kullanıyor. Araştırmanın başlığı “biyolojik olarak parçalanabilen 3B baskı mantar pil”.
Pil, ömrünü tamamladığında bozunmaya ve kendini içeriden sindirmeye başluyor. Pil, iki tür mantarın karışımından oluşuyor. Anot tarafında metabolizması elektronları serbest bırakan bir maya mantarı bulunuyor. Katot için araştırmacılar, özel bir enzim üreten beyaz çürükçül mantar kullanıyor. Bu enzim elektronların yakalanıp hücre dışına taşınmasını sağlıyor.
Empa araştırmacıları, bu buluşun bir pilden ziyade mikrobiyal bir yakıt hücresine benzediğini vurguluyor. Bu iki mantarı pile yerleştirmiyorlar çünkü onlar zaten başından beri onun bir parçası. Araştırmacılar, 3B yazıcıları kullanarak mantar hücrelerini parçalanabilir selülozdan yapılan baskı mürekkebinde birleştiriyor. Sonuç olarak onlara mantarlardan yapılmış, 3B baskı ve biyolojik olarak parçalanabilen bir pil ortaya çıkıyor. Elektriksel olarak yeterince iletken ve hücreleri öldürmeden yazıcıdan çıkarılması kolay.
Ömrünü tamamladığında kendini sindirmeye başlıyor
Şimdilik, başta (sıcaklık) sensörleri olmak üzere küçük cihazları çalıştırabiliyor ve birkaç gün dayanabiliyor. Tarımda veya çevre araştırmalarında avantaj sağlayabileceği düşümülüyor. Buna ek olarak pil, geleneksel pillerin aksine toksik değil, çünkü araştırmacılar bunu üretmek için mantar gibi biyolojik olarak parçalanabilen doğal malzemeler kullanıyorlar.
3B baskıda kullanılan mürekkebin içinde ahşap, pamuk ve diğer doğal elyaflardan elde edilen selüloz bulunuyor. 3B baskı biyobozunur pildeki mantar hücreleri, bu selülozu bir besin maddesi olarak da kullanabiliyor, bu da kullanımdan sonra kendi kendini parçalamasına yardımcı oluyor. Ancak araştırmacılar, doğal araçlarının tercih edilen besin kaynağının basit şekerler olduğunu ve dolayısıyla bunları zaten basılı ürüne eklediklerini söylüyor. Kullanıcıların 3B baskılı biyolojik olarak parçalanabilen pili kurutulmuş halde veya balmumundan yapılmış muhafazada saklayabileceklerini de ekliyorlar. Kullanıcı bunları aktive etmek veya güç sağlamak için kullanmak istediğinde, bunu su ve besin maddeleri, yani basit şekerler ekleyerek yapabiliyor.

Görsel: Empa







